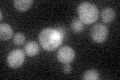
YER152C
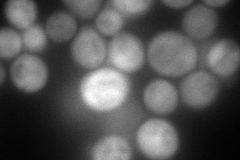
YER152C
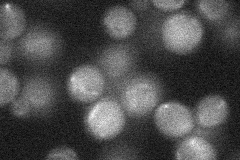
YER152C
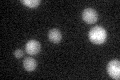
YER152C

View description
Protein with 2-aminoadipate transaminase activity; shares amino acid similarity with the aminotransferases Aro8p and Aro9p; YER152C is not an essential gene
Localization:
Intensity:
Fold change:
Significance:
-
C’ GFP library in SD
cytosol27.64 -
N' NOP1pr-GFP in SD

cytosol147.002 -
N' TEF2pr-mCherry in SD
cytosol184.976 -
N' NATIVEpr-GFP in SD
below threshold23.2476 -
N' TEF2pr-VC and Cyto-VN in SD

#N/A0 -
C’ GFP library in SD+DTT

cytosol33.61.21No -
C’ GFP library in SD+H2O2

cytosol31.171.12No -
C’ GFP library in Starvation Media
cytosol31.181.12No -
C’ GFP library on the background of Pup2-DaMP

N/A -
C’ GFP library on the background of CCT mutant

N/A0N/AYes
